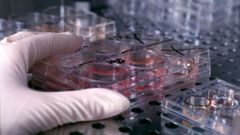
En todo el mundo se est�n realizando investigaciones para encontrar una vacuna o un tratamiento para el SARS-CoV-2

27 oct 2020

Un hombre que triplicaba la tasa de alcoholemia provoca un accidente en El Entrego
La Policía Local detuvo además a una joven que manifestó una actitud violenta con insultos y tentativas de agresión hacia sus abuelos
La Voz